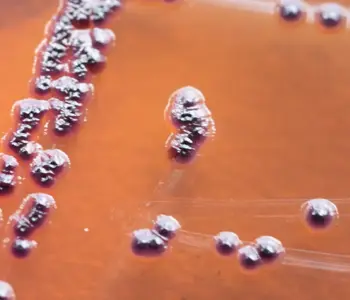

To support our environmental consultant clients, CTS Water Microbiology provides a wide range of analytical testing services for soil microbiology – accurately detecting contamination to inform safe, compliant decision-making.
Our Soil Microbiology Services
CTS Water Microbiology also specialises in analysing soil samples to detect the presence of microorganisms. Our testing on soils can include key indicator organisms such as E. coli, coliforms and Enterococci. Depending on your requirements, we can also identify soil contamination of Sulphate Reducing Bacteria, Sulphite Reducing Clostridia, and Clostridium Perfringens.
Our comprehensive soil microbiology testing services cater to construction, environmental consulting, and waste management industries. Whether you are assessing a potential site for development or managing ongoing remedial efforts, we can help ensure your site is safe and compliant.

Soil Microbiology: Sulphite Reducing Clostridia (SRC)
One of the key microorganisms we test for in soil is Sulphate Reducing Clostridia (SRCs), which can be found in human and animal faecal waste, wastewater, and soil. Their presence in soil often indicates faecal contamination, making their presence in water an indication of faecal or soil contamination.
Clostridium Perfringens is a type of sulphite-reducing species. As a reliable indicator of historical faecal contamination and a common cause of food poisoning, C Perfringens is one of the most important in water and soil microbiology.

CTS for Professional Soil Microbiology Services
With years of experience in water and soil microbiology, CTS Water Microbiology has built a reputation for delivering high-quality, reliable testing services. Our UKAS*-accredited laboratory and dedicated team ensure that every sample is handled with precision and care, providing prompt, accurate results to help you make informed decisions about your site.
Whether you are working on a new construction project or managing contaminated land our soil microbiology services provide critical insights into your environment’s condition. We work closely with you to address your unique needs, ensuring you receive the most relevant and valuable testing possible.
* For a full list of our UKAS-accredited activities, please view our schedule of accreditation.

To learn more about our microbiology and chemistry testing services and how we can help you, contact the CTS Water Microbiology team today!